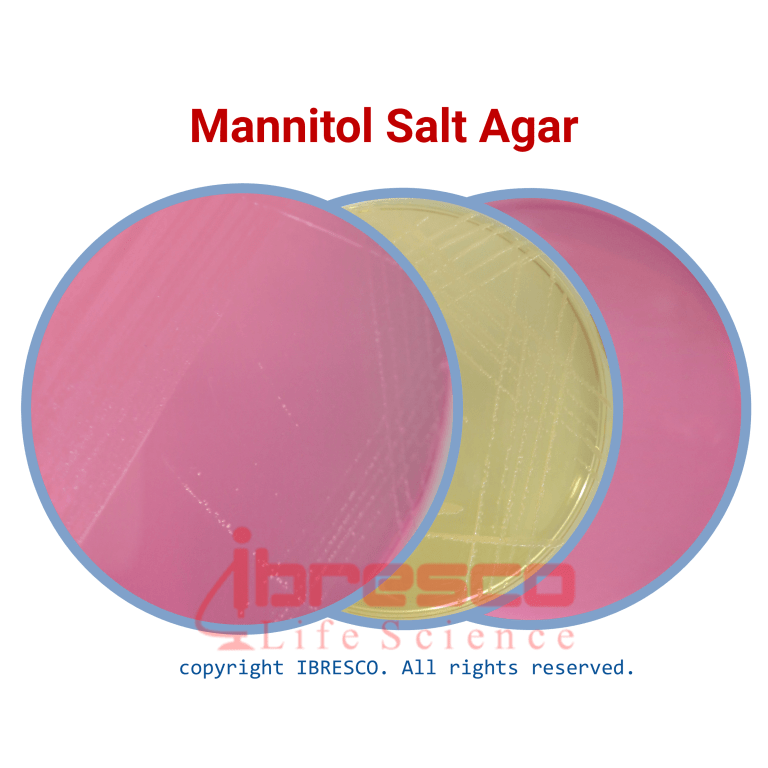

Mannitol Salt Agar | مانیتول سالت آگار ایبرسکو
کاربرد: محیطی انتخابی جهت جداسازی و شمارش استافیوکوک های بیماری زا از مواد غذایی، نمونه های بالینی و غیره.
استانداردها: BAM, USP, EP, JP
ویژگی ها
- ضمانت اصالت کالا
- ارسال سریع کالا
- مشاوره کاهش هزینه ها
- خرید بهترین برندهای خارجی و داخلی با قیمت مناسب
- پشتیبانی 24 ساعته
- امکان سفارش در حجم و اندازه مورد نیاز بسیاری از محصولات
- 8161 351 935 98+
کاربرد: محیطی انتخابی جهت جداسازی و شمارش استافیوکوک های بیماری زا از مواد غذایی، نمونه های بالینی و غیره.
استانداردها: BAM, USP, EP, JP
آماده سازی محیط
- قوطی محیط کشت مانیتول سالت آگار را به خوبی تکان دهید. مقدار ۱۰۸ گرم از پودر محیط را در ۱ لیتر آب مقطر حل کنید.
- به آرامی حرارت داده و به مدت چند ثانیه بجوشانید تا محیط بطور کامل حل شود.
- محیط کشت را به مدت ۱۵ دقیقه در دمای ۱۲۱ درجه سانتی گراد اتوکلاو کنید.
شرایط نگهداری
پودر محیط داخل قوطی کاملا در بسته و در دمای زیر ۳۰ درجه سانتی گراد و محیط آماده در دمای ۸-۲ درجه سانتی گراد نگهداری شود. بهترین زمان استفاده تا قبل از تاریخ انقضای درج شده بر روی برچسب محصول است.
آزمایش
فرآیند آزمایش
- نمونه مورد نظر را بر روی محیط، کشت دهید. با توجه به بالا بودن خاصیت مهارکنندگی این محیط کشت، نمونه باید در حجم بالا کشت داده شود.
- پلیت ها را به مدت ۳ روز در دمای ۳۵ درجه سانتی گراد گرماگذاری کنید.
نتیجه و تفسیر
در این نوع محیط کشت، باکتری هایی که می توانند در حضور مقادیر بالای نمک رشد کرده و مانیتول را تخمیر کنند، اسید تولید می کنند که در این صورت، رنگ شناساگر pH که در این محیط فنول رد می باشد، از قرمز به زرد تبدیل می شود. بنابراین، استافیلوکوک های کواگولاز مثبت، کلنی های زرد رنگ با هاله زرد تولید می کنند و استافیلوکوک های کواگولاز منفی، کلنی های کوچک قرمز رنگ و بدون هیچ تغییر رنگی در محیط کشت تولید خواهند کرد.
میکروکوکوس ها، بصورت کلنی های بزرگ سفید مایل به نارنجی و بدون تغییر رنگ در محیط کشت مشاهده خواهند شد.اکثر باکتری های دیگر در این محیط کشت مهار خواهند شد.
نکته
رشد اکثر باکتری های دیگر در این محیط کشت مهار خواهد شد.
کنترل کیفی
- ظاهر پودر: بژ روشن، یکدست و پودری، گاهی اوقات همراه با دانه های سیاه تا قرمز رنگ.
- ظاهر محیط آماده: محلول قرمز – نارنجی رنگ، شفاف تا کمی کدر
- نتیجه کشت باکتری در شرایط هوازی پس از گرماگذاری در دمای ۲±۳۵ درجه سانتی گراد به مدت ۷۲-۴۸ ساعت
| تغییر رنگ محیط کشت اطراف کلنی | رشد | ATCC | سوش استاندارد |
|---|---|---|---|
|
زرد
|
خوب
|
25923
|
Staphylococcus aureus
|
|
N/A
|
رشد دارد
|
6538
|
Staphylococcus aureus
|
|
قرمز
|
خوب
|
12228
|
Staphylococcus epidermidis
|
|
N/A
|
عدم رشد
|
8739
|
Escherichia coli
|
|
–
|
مهار جزئی تا عدم رشد
|
12453
|
Proteus mirabilis
|
| گرم بر لیتر | ترکیبات |
|---|---|
|
10.0
|
Peptones
|
|
1.0
|
Meat Extract
|
|
75.0
|
Sodium Chloride
|
|
10.0
|
D(-) Mannitol
|
|
0.025
|
Phenol Red
|
|
12.0
|
Agar
|
|
0.2 ± 7.4
|
Final pH
|
محصولات پیشنهادی
دیدگاهها
حذف فیلترهاهیچ دیدگاهی برای این محصول نوشته نشده است.